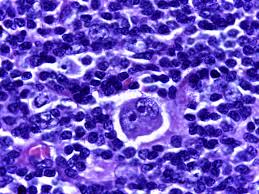
download

Lymphoma is a form of cancer in the blood that affects the lymphatic system. It is an essential component in the immune system of our body. The lymphatic system is comprised of lymph nodes, spleen, bone marrow, as well as other tissues that help protect your body against infection and illnesses. If lymphocytes, a type of white blood cells – bexpand uncontrollably, they create lymphomas, which can lead to cancer. There are two main categories: Hodgkin lymphoma (HL) and non-Hodgkin lymphoma (NHL). Although both are lymphatic cancers, they differ in their treatment. system however, they differ in their the types of cells, symptoms, treatments, and prognosis.
What Is Hodgkin Lymphoma?
Hodgkin lymphoma is an extremely rare type of lymphoma making up about 10 percent of all cases of lymphoma all over the world. The most distinctive feature for HL is its presence Reed-Sternberg lymphoma cells which are huge abnormal lymphocytes, visible under microscope. These cells play a crucial part in diagnosing the condition.
Key Features of Hodgkin Lymphoma
-
The age group Most often is a problem for young adults between 15 and 35 years, and adults older than 55.
-
Location The majority of cases begin within lymph nodes of the upper part of the body, which includes the chest, neck, and underarms.
-
Spread pattern The pattern typically the spread pattern is ordered from one lymph nodes to the next.
Common Symptoms
-
The lymph nodes are swollen and painless
-
Night sweats
-
Persistent fatigue
-
Unusual weight loss and fever
-
Skin rashes or itching (in certain cases)
The symptoms could be mild at first, which is the reason the medical evaluation should be done as soon as possible to ensure timely diagnosis and treatment.
What Is Non-Hodgkin Lymphoma?

Non-Hodgkin lymphoma is more frequent, comprising about 90% of lymphoma cases. In contrast to HL, NHL includes more than 60 subtypes that range in growth rates from low (indolent) to more aggressive versions. The illness is not contain Reed-Sternberg cells which is the primary distinction in the case of Hodgkin lymphoma.
Key Features of Non-Hodgkin Lymphoma
-
Age range It can happen at any age, however the risk is higher with the age.
-
Location The cause of HTML0 is lymph nodes, but may be found in stomach, intestines or even on the skin.
-
Spread pattern grows in an unpredictable, non-orderly manner and can cause problems with the diagnosis and treatment.
Common Symptoms
-
Large lymph nodes in the armpit, neck or the groin
-
Abdominal discomfort or swelling
-
A difficulty breathing or chest pain
-
Fatigue, weight loss that isn’t intentional and night sweats
-
Infections are frequent due to weakening immunity
Since NHL can be found in a variety of organs and tissues, the symptoms can differ widely based on the subtype as well as the location of involvement.
Hodgkin vs. Non-Hodgkin Lymphoma: Main Differences
| Feature | Hodgkin Lymphoma (HL) | Non-Hodgkin Lymphoma (NHL) |
|---|---|---|
| Key Cell | Reed-Sternberg cells present | No Reed-Sternberg cells |
| Prevalence | 10% of the cases | 90 percent of the time |
| Age Group | Young adults & 55+ | Any age, but often adults |
| Spread Pattern | Orderly, predictable | Random, non-linear |
| Common Locations | Underarms, chest, neck | Lymph nodes, stomach, skin, intestines |
| Treatment | High cure rates using chemo/radiation | Subtypes vary, and some are more difficult to treat |
| Prognosis | 5-year survival rate of 85-90 percent (early stages) | It varies widely (60-85 percent depending on the stage or type) |
There is a presence of Reed-Sternberg cell within HL and the consistent pattern of spreading are the most significant distinguishing characteristics. NHL is a complex disease, with a variety of subtypes, is more difficult to recognize and manage effectively.
Treatment Approaches
Hodgkin Lymphoma
Therapies for Hodgkin lymphoma typically has a high rate of success particularly when it is detected in the early stages. Most common treatments comprise:
-
Chemotherapy Chemotherapy: ABVD: ABVD protocol (Adriamycin, Bleomycin, Vinblastine and Dacarbazine) is often employed.
-
Therapy with radiation is used to treat localized diseases to target the lymph nodes that are affected.
-
Stem cells transplant to treat the possibility of relapse or for resistant cases.
-
Therapy targeted and immunotherapy for advanced or difficult-to-treat patients, more advanced therapies are being utilized to enhance the outcomes.
Non-Hodgkin Lymphoma
NHL treatment is contingent on the subtype and the severity of the disease
-
Chemotherapy The CHOP treatment (Cyclophosphamide, Doxorubicin, Vincristine and Prednisone) is the standard treatment for many kinds.
-
Immunotherapy Rituximab is typically used to treat B-cell NHL subtypes.
-
CAR-T therapy is a novel treatment for relapsed or aggressive NHL.
-
Stem cells transplant for selected patients suffering from high-risk or resistant disease.
-
Radiotherapy Used to treat targeted tumors, when needed.
Due to the wide variety of NHL different subtypes and types of treatment strategies are extremely individualized to improve results.
Prognosis and Survival
Hodgkin Lymphoma generally is among the top rates of cure among cancers. Early-stage HL has an five-year rate of survival between 85 to 90 percent so timely diagnosis is vital. Remission for a long time is possible for a lot of patients who receive appropriate treatment.
Non-Hodgkin’s Lymphoma is a type of cancer that is largely dependent on the stage and subtype. Insidious forms can be treated for a long time with continuous treatment and monitoring, while more aggressive ones require immediate and extensive treatment. The survival rates vary between 60 to 85 percent and highlight how crucial it is to detect early and accurate subtype recognition.
When to See a Hematologist
Early detection greatly improves the outcome of treatment with regard to as well HL as well as NHL. Any patient who is experiencing persistent symptoms like:
-
The lymph nodes are swollen and don’t resolve
-
Night sweats
-
A strange fever or loss of weight
-
Persistent fatigue
You should see with a physician as well as an oncologist immediately. A lot of lymphomas can be treated when detected at a young stage. If you ignore these warning signs, it can delay treatment and lower the chance of a favorable outcome.
Conclusion
Although both Hodgkin lymphoma as well as non-Hodgkin lymphoma have an impact on the lymphatic system their distinctions in cell types and manifestations, spread patterns, and treatment strategies are essential in the management and diagnosis. Hodgkin lymphoma is less prevalent it has a higher chance of being cured, especially if detected early. Non-Hodgkin Lymphoma, which is more frequent and varied and requires a specific treatment plan based on the type and stage. Early recognition of symptoms, medical consultation and the latest developments in targeted therapies have dramatically improved the prognosis of patients suffering from the two kinds of lymphoma.
Knowing these distinctions allows caregivers, patients, and medical professionals in taking active steps towards being able to recognize, diagnose and treating lymphomas efficiently.

